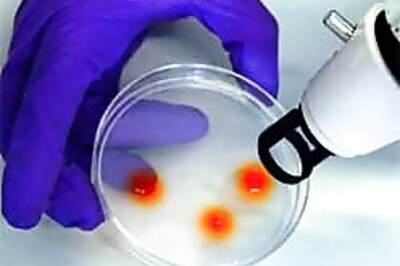
A new outsourcing to hit Indian labs

News
Chevy sports hits the road, mini to chase
GM will also launch a CNG variant of its premium sedan Optra next month and plans to introduce a diesel variant.
Ronaldo, the best striker now: Muller
Ronaldo in Brazil’s match against Ghana, broke Muller’s record of maximum of number of World Cup goals.
Volvo Cars to start sales in India, EU
Volvo expects increase in new-car sales from one million per year to 1.6 million over a four-year period in India.
Sex racket: J&K lawyers on strike
The Jammu Bar went on a strike to condemn a threat issued to a senior lawyer in the sex scandal case.
Japanese women pay to feel loved
Host clubs in Tokyo have employed more than 170 gigolos to ply their trade in a glitzy nightclubs.
Sahara to sue Jet for Rs 2,000 crore
Following the scrap of the Jet-Sahara deal, both the parties moved to court to stop the other party from operating the escrow account.
LTTE 'sorry' for killing Rajiv Gandhi
An LTTE leader apologised to India for the assassination of former PM Rajiv Gandhi, by a Tiger suicide bomber.
We didn't terminate Sahara deal: Jet
Jet Airways on Tuesday gave a new twist to the Air Sahara deal issue, saying that it did not terminate the agreement.
Drinking coffee may lower diabetes risk
Women who drink more coffee are 22 per cent less likely to develop diabetes than those that drink no coffee.
Two fighter jets collide in California
Two Navy fighter jets collided over a military base, killing one pilot and injuring another, authorities said.
Enable parity for women: Defence Minister
Women in the armed forces can now look forward to getting ranks and salaries equal to their male counterparts.
US to deploy intercept missiles in Japan
Japan and the US agree to deploy advanced Patriot interceptor missiles on US bases in Japan.
Court serves notice on Salman
A Jodhpur court has issued a show-cause notice to Salman for submitting a false affidavit regarding the poaching case.
Super premiere for Superman Returns
Stars of Superman Returns turned up for the film's premiere in Los Angeles on Thursday.
A new outsourcing to hit Indian labs
Indian labs offer a comprehensive test menu - over 1,500 tests under one roof at about 70 to 80 per cent less costs.
Blacken Taslima Nasreen's face: Cleric
A leading Muslim cleric on Sunday issued a fatwa that the face of controversial Bangladeshi writer Taslima Nasreen.